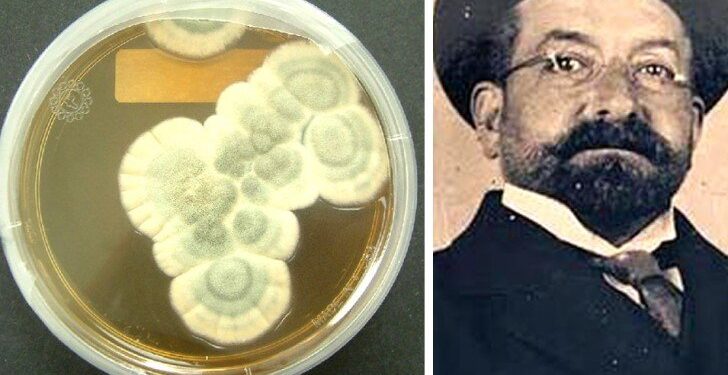
L’acqua ossigenata contro il Covid e Vincenzo Tiberio che anticipò Fleming

Napoli misconosciuta terra di genio
Secondo Antonio Del Prete, docente di oftalmologia dell’Università Federico II di Napoli, dei semplici gargarismi con acqua ossigenata sarebbero sufficienti per prevenire il contagio da coronavirus. Lo studio è stato pubblicato sulla rivista Infection Control & Hospital Epidemiology dell’Università di Cambridge e ripreso e confermato dai ricercatori dell’ospedale Sacco di Milano.
La vera notizia sta nel fatto che il Ministero della Salute, impegnato in operazioni miliardarie senza precedenti per il contrasto dell’epidemia in corso, ritiene che non ci siano 200mila euro per sovvenzionare lo sviluppo e la conferma di tali osservazioni.
Sarà perché in fatto di disconoscimento di primati meritori Napoli non ha rivali, ma questa notizia mi ha fatto tornare in mente la storia di Vincenzo Tiberio (1869 – 1915), l’uomo che, ancora umile studente di medicina, notò come le muffe che crescevano nel pozzo cisterna dello zio premunissero i contadini dal prendersi il tifo. Nonostante l’ostracismo dei cattedratici di Napoli, il nostro, dopo anni di studio e di lotte, pubblicò nel 1895 sugli “Annali di Igiene Sperimentale”, ben 35 anni prima di Fleming, uno studio sul potere battericida delle muffe.
Ma perché questa osservazione rivoluzionaria e per di più lineare e limpida nella sua dimostrazione, passò completamente sotto silenzio, mentre 35 anni dopo la stessa valse a Fleming uno dei più celebrati premi Nobel per la medicina?
Psicopatologia della scoperta scientifica
C’è una caratteristica della scienza in generale che non si drovrebbe mai dimenticare, ed è quella legge non scritta secondo cui qualsiasi scoperta scientifica, per essere considerata vera, deve essere prima di tutto accettabile ovvero concepibile da parte di coloro che pretendono di capirla. Di fronte agli idolatri della scienza moderna, agli adulatori della medicina basata sull’evidenza, una simile affermazione non può che risultare blasfemia, eppure nella nostra storia esempi utili a corroborare un simile persuasione non mancano. La pretesa oggettività della scienza, la sacra legge della riproducibilità dell’esperimento scientifico, l’unanimità della comunità scientifica, sono ben poca cosa rispetto alle nevrosi collettiva.
Pregiudizio tecnologico
Si potrebbe obiettare che la storia di Tiberio è in fondo quella di tutti i precursori, la stessa storia di tutti i “Galileo” che sono stati sopraffatti dall’ottusità del proprio tempo e dall’oscurantismo in tutte le sue varie forme, con le quali ogni epoca deve immancabilmente misurarsi, perché il cambiamento incontra sempre delle resistenze.
C’è un particolare che distingue però Galileo da Tiberio, un particolare che rende Tiberio una vittima della scienza moderna, vittima cioè di un pregiudizio che ai tempi di Galileo non vi era, un pregiudizio diverso, nuovo, moderno insomma. Il pregiudizio che vuole come più scientifico ciò che è più tecnologico. Quello che non si poteva accettare della scoperta di Tiberio non era infatti la novità in se, ma il fatto che la sua intuizione avesse origini tanto umili come le muffe del pozzo dello zio e forse anche il fatto che le sue dimostrazioni fossero tanto semplici. Il pensiero positivista imperante faceva credere allora come oggi che la soluzione sarebbe nata tra ampolle fumanti e bricchi di laboratorio, frutto di complicate reazioni chimiche o di equazioni mirabolanti.
Anche oggi lo stesso pregiudizio, figlio dell’immaginario odierno, vuole che le grandi scoperte vengano fatte in grandi laboratori, con l’utilizzo di tecnologie avanzatissime ad opera di nutrite equipe internazionali di scienziati riconosciuti dall’accademia. Eppure la storia ci insegna proprio il contrario, e cioè che più spesso sono stati dei singoli e misconosciuti individui di genio, che con tenacia e con scarsi mezzi hanno donato al mondo le loro grandi intuizioni, gli stessi che di sovente sono stati compresi solo molto dopo il loro tempo. Ma la storia si ripete proprio perché non si riesce a prescindere da certi schemi che prima di essere scientifici, sono umani, politici, psicologici e sociali.
Il circolo vizioso tra tecnica ed economia che distrugge ogni progresso del pensiero
Sarebbe di certo chiedere troppo di avere al governo persone capaci di prescindere dal pregiudizio tecnologico, ma capire l’importanza preponderante che vi è oggi di supportare il più possibile una ricerca nazionale sovvenzionata dallo Stato, che sia quindi libera e indipendente dai grandi poteri economici, sarebbe invece il minimo sindacale.
La totale mancanza di indipendenza della ricerca da interessi commerciali privati, non sembra però scalfire le certezze degli adulatori della scienza che a questo punto si stanno trasformando con totale noncuranza in adulatori del logo di turno. In questo modo l’intreccio tra pregiudizio tecnologico e dipendenza economica della ricerca dagli enormi fondi privati di cui abbisogna, si è trasformato in uno specchietto per le allodole capace di attirare a se l’attenzione di tutti ed impedendo lo sviluppo di un progresso del pensiero alternativo, specie se frutto di osservazioni semplici e capace di fornire soluzioni a basso costo.